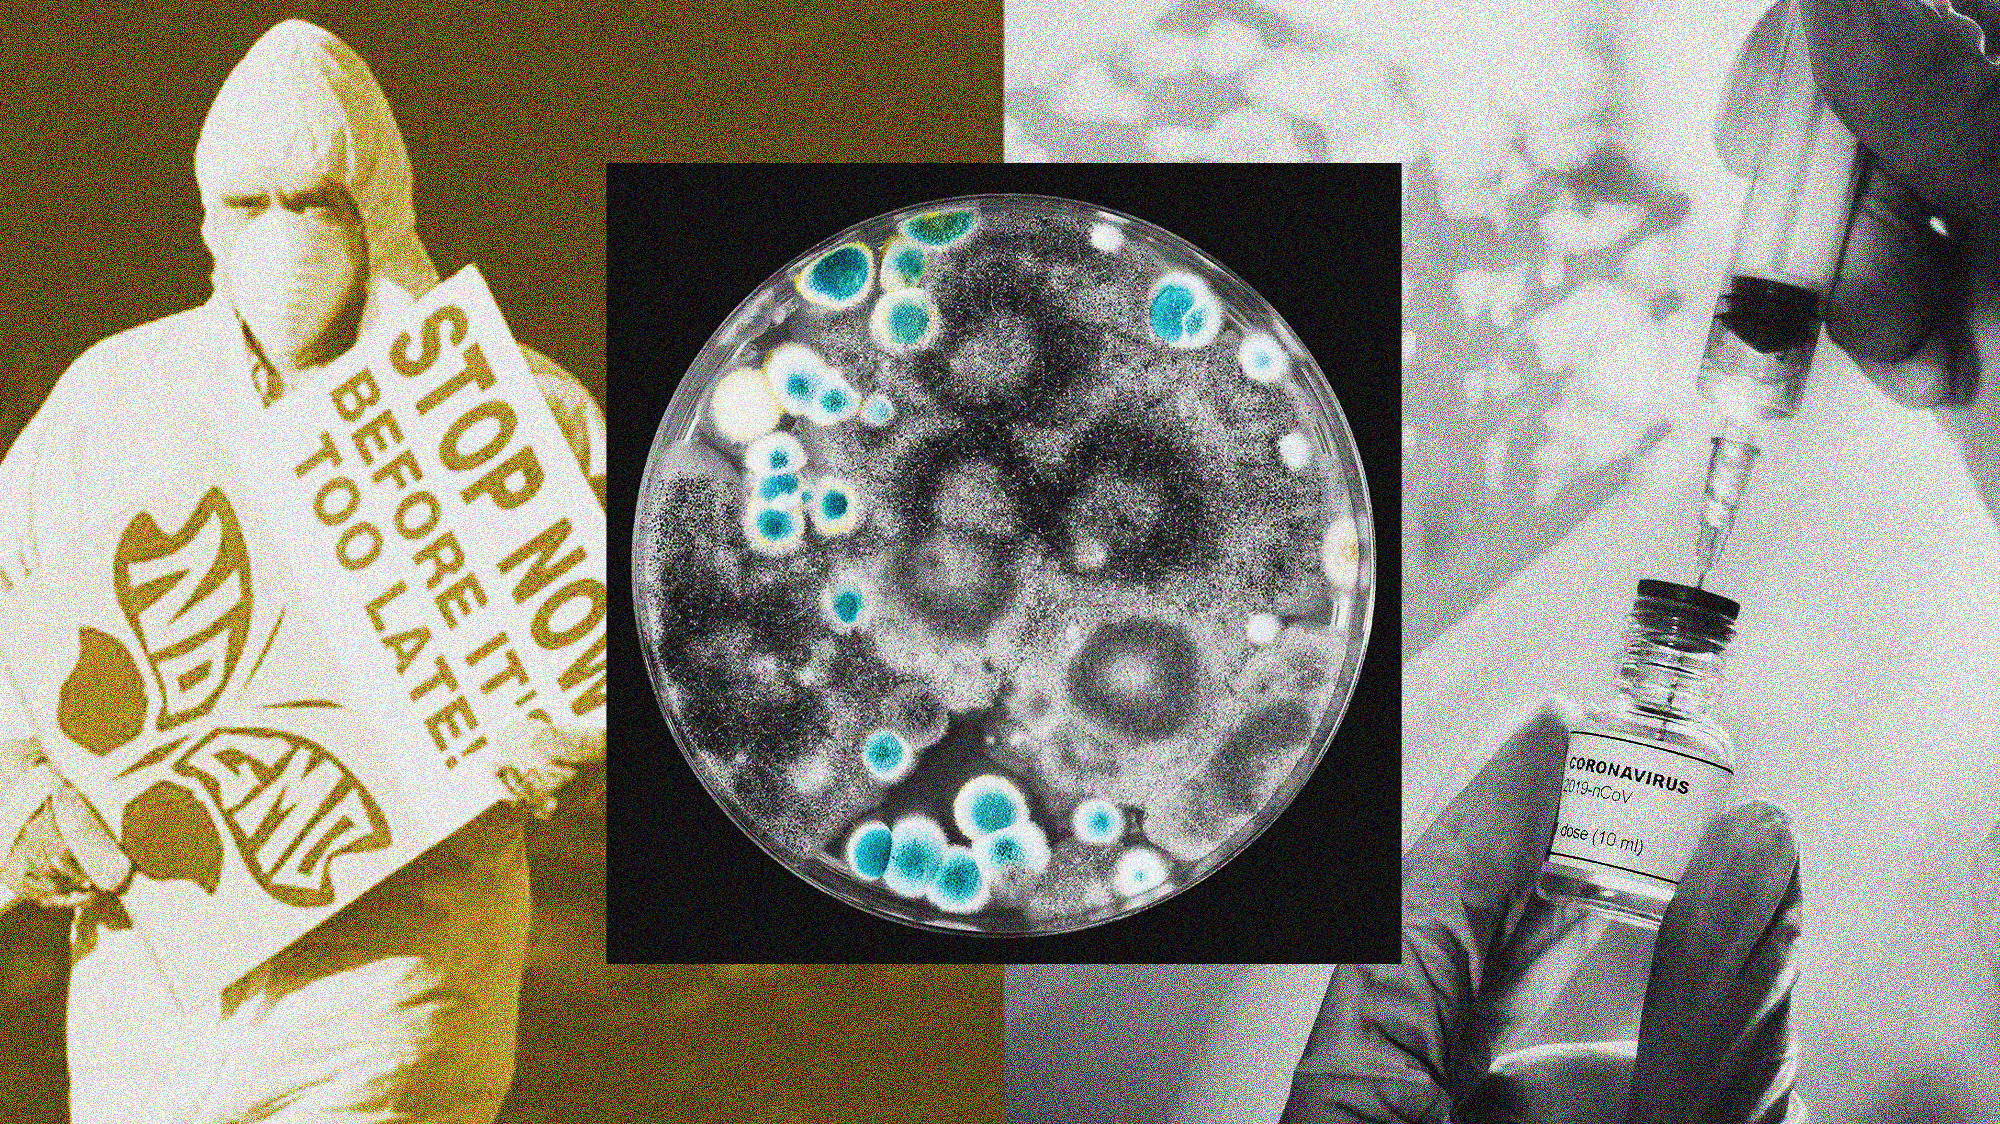

The Center for Food Safety is the kind of organization that most progressive foodies can get behind: Its website features photos of graceful monarch butterflies and dairy cows with big, doleful eyes. Its recent campaign slogans implore supporters to “tell EPA to stop this brain-damaging pesticide!” and “protect dolphins and birds from floating factory farms!” It advocates for farmworker rights, humane treatment of animals, and protection of pollinators.
Oh, yes, and there’s one more thing: The 24-person nonprofit, whose revenue in 2019 was about $5.2 million, wants the US government to stop supporting certain kinds of high-level virology research. Last month, the group sued the National Institutes of Health in an attempt to force the agency to reveal information about its funding for what is known as “gain-of-function” research—the term refers to a category of lab work that seeks to understand how viruses create pandemics. Sometimes, but not always, the research involves manipulating viruses to make them more virulent and contagious to study how they evolve.
Virologists say this kind of research is vital and has led to many important medical discoveries, including during the COVID-19 pandemic. But Center for Food Safety argues that gain-of-function research is too dangerous to pursue. A pathogen released from a lab “could result in catastrophic consequences to the human environment,” CFS staff attorney Victoria Yundt warned in a recent press release about the NIH law suit. Andrew Kimbrell, a public interest attorney who founded the Center for Food Safety in 1997, was also quoted in the release saying, “The NIH’s refusal to make public the research it is funding to enhance the transmissibility, infectiousness, and lethality of potential pandemic viruses is grossly irresponsible.”
Why would this lefty food and farms group—and they aren’t alone—rail against high-level virology research? The key to the answer has to do with the Center for Food Safety’s long opposition to the practice of genetic engineering. In a recent phone call, I spoke to CFS’s Kimbrell, who explained what he sees as the connection. “You genetically engineer bacteria and plants, then you genetically engineer animals, then you genetically engineer embryos—all that has happened, with some promise, but also a tremendous amount of danger and threat,” he said. “Now, viruses are not technically an organism, but they are living biological elements. So, they fit certainly within that narrative: Just because we can do something doesn’t mean we should do something.”
Kimbrell said he “absolutely” thinks the pandemic was the result of an accidental lab release. Scientists at the Wuhan Institute of Virology, he believes, used gain-of-function to enhance a coronavirus. The virus then escaped out of the lab, spread uncontrollably, and caused the COVID-19 pandemic. Hence, in effect, gain-of-function research caused the pandemic.
Kimbrell isn’t the only genetic-engineering critic who has come out against gain-of-function research and in favor of the lab-leak theory. Over the past few months, many organizations that once busied themselves warning the public about pesticides in breakfast cereal and the evil deeds of Monsanto have pivoted to protesting gain-of-function work. Organic Consumers Association, a nonprofit that advocates against pesticides and genetic engineering of food, published a “hall of shame” series on virology researchers who use the technique. “As we follow the evidence—and follow the money—we come face to face with a cast of out-of-control Mad Scientists, militarists and biotech/bio-pharmaceutical entrepreneurs,” one recent post reads.
US Right to Know, a nonprofit that advocates for transparency around genetically modified food, announced in May that it “is expanding its investigative work into other urgent public health matters, including the origins of the novel coronavirus SARS-CoV-2, which causes the disease COVID-19.” Robert F. Kennedy, Jr.’s anti-vaccination advocacy group Children’s Health Defense, which has also criticized genetic engineering, has taken up the campaign against gain-of-function and embraced the hypothesis that these experiments made COVID-19 more dangerous—not to mention that it then may have escaped from a lab. The website of the International Center for Technology Assessment, an anti-GMO group that Andrew Kimbrell founded alongside Center for Food Safety, now seems almost entirely devoted to criticizing gain-of-function and promoting the lab-leak hypothesis.
Over the last year, I have watched online anti-vaccine groups radicalize parents, starting with questions about shots and then moving them into pandemic-denying conspiracy theory adherents. I’ve noticed that even in our politically polarized world, the political spectrum isn’t always a straight line; sometimes it’s a circle where at a certain point in the back, the far left and the far right converge.
I am now watching the same dynamic play out in anti-GMO groups, as environmentalists who worry about pollinators get drawn into a dark narrative that vilifies vital research. With tens of thousands of followers on social media, anti-GMO groups have the potential to turn the tide of public opinion; hanging in the balance is science that could potentially help prevent the next pandemic.
Also at stake is the reputation of scientists themselves. When I asked Kimbrell why researchers would willingly undertake gain-of-function experiments if they really were both dangerous and unnecessary, he told me that he believes that the basic motivation could be found in the inflated egos of researchers. “For some reason, there’s always this altruistic halo around scientists, but you know, they created nuclear weapons, science has created all the chemicals that are polluting our air and our environment,” he said. “I think there’s a huge amount of sort of just, ‘Let’s do it, because we can and it’s exciting.’ Like crossword puzzles.”
Since the lab-leak hypothesis has dominated the news recently, let me back up. My suspicion is that no one will ever know for sure where the virus came from, though most scientists agree that the United States and China must conduct a thorough investigation into its origins. Scientists also agree about the paramount importance of lab safety; if you’re interested in learning more about lab leaks, I urge you to read this piece by Rowan Jacobsen that Mother Jones published a year ago.
To be fair to the opponents of gain-of-function research, most experts agree that some extreme versions of this work are truly reckless. As Jacobsen wrote, lab leaks have occurred with some frequency over the past few decades. An early controversy over gain-of-function research came to a head in 2011, when University of Wisconsin researcher Yoshihiro Kawaoka announced that his lab had successfully modified the highly lethal H5N1 bird flu to make it airborne among ferrets. After much media criticism of this experiment, in 2014, the Obama administration placed a moratorium on most gain-of-function experiments the US funded throughout the world. The Trump administration mostly lifted the restriction in 2017, though at the onset of the pandemic, the former president decried the practice and claimed that the US funding of such work in China was a relic of the Obama administration. (That wasn’t exactly true; after all it was his administration who did away with the moratorium.)
Last month, after more stories about the Wuhan lab appeared, the US Senate approved an amendment put forth by Sen. Rand Paul (R-Ky.) that would permanently halt US funding of gain-of-function research in China. “While many still deny funding gain-of-function research in Wuhan, experts believe otherwise,” Sen. Paul said in a press release. “The passage of my amendment ensures that this never happens in the future.”
Yet the virus researchers I spoke with emphasized that not all gain-of-function research is dangerous—to the contrary, most of it is quite routine and has been crucial in advancing disease research and treatment. Gerald Keusch, an infectious disease specialist who is a co-director of Boston University’s National Emerging Infectious Diseases Laboratories, points out that the term “gain-of-function” is frustratingly broad and describes a large swath of virus work. “Most scientists will say that gain-of-function is too crude a terminology,” he told me. “It encompasses things that are necessary and safe, to things that are necessary but somewhat risky, to things that are maybe not necessary and highly risky. And they all get wrapped under the same term.” He points out that some landmark medical breakthroughs happened because of gain-of-function: For example, the technique led to University of North Carolina scientists’ discovery that the drug remdesivir could treat COVID-19. Indeed, work under the broad category of gain-of-function also may have contributed to the vaccine research on other coronaviruses that hastened the development of the COVID-19 vaccines, Keusch added.
The outcry over gain-of-function research has cast a pall of suspicion over other, completely unrelated kinds of pandemic research. Peter Daszak, the president of nonprofit EcoHealth Alliance, has seen this play out firsthand. EcoHealth Alliance, which has an annual budget that ranges from $10 million to $17 million, a US-based staff of about 50, and some contractors abroad, came under scrutiny last April, when media reports revealed that the organization had earmarked about $600,000 of a $3.4 million NIH grant to fund preapproved research at the Wuhan Institute of Virology. In the wake of these reports, the Trump administration canceled the entire NIH grant for EcoHealth Alliance—even the parts that had nothing to do with the Wuhan lab.
This move struck Daszak as bizarre. “We don’t even have a lab,” he told me. “We do things like produce a book on how to live safely with wildlife or educate community leaders.” Despite the actual nature of his work, over the past year, he and EcoHealth Alliance somehow have become the symbols of gain-of-function research. The GMO-transparency group US Right to Know recently filed 74 requests under the Freedom of Information Act that tied up EcoHealth’s board members and funding agencies for months. “They know that a small organization like ours cannot keep up with that level of work,” Daszak said. He finds irony in anti-GMO groups’ crusade against his work. “You’ve got these anti-GMO groups trying to shut us down when here we are trying to achieve the same goal,” he said, “which is a more balanced relationship with nature.”
The overlap that Daszak describes reflects a complicated political dynamic. The anti-GMO movement used to reside comfortably on the left: A 2001 ABC News survey found that Democrats were far more likely than Republicans to believe that genetically modified foods were unsafe, and Democratic politicians have fought hard for the mandatory labeling of these foods. Science writers have called the movement against GMOs the left’s anti-science problem. But that may be changing: A 2016 Pew survey found that equal numbers of Democrats and Republicans believe that “GMOs are worse for people’s health.” That same year, when the Senate was divided over a controversial GMO-labeling bill, many Democrats argued it didn’t go far enough in requiring companies to disclose genetically engineered ingredients. But others defended the measure. “It will provide fair and objective information without stigmatizing foods that are completely safe,” Indiana’s Democrat Sen. Joe Donnelly said. Sen. Debbie Stabenow (D-Mich.) spoke of the “scientific consensus that biotechnology is safe.” (The bill passed 63–30, and the law set to go into effect later this year.)
But now, this past year, anti-GMO groups’ gain-of-function criticism has drawn more attention from the right. Center for Food Safety’s Kimbrell said that in the weeks since his group sued the NIH over gain-of-function transparency, he has been invited to speak on several right-wing talk shows. (He declined.) And until recently, the idea that COVID-19 could have come from a lab was considered mostly a right-wing theory, promoted with a few racist dog whistles by President Trump and his supporters. Anti-GMO groups don’t typically endorse that kind of rhetoric, but with their embrace of the lab-escape theory, they couldn’t help but attract it. I noted a xenophobic flavor to many of the comments on several of the groups’ social media posts referencing COVID. In response to a recent US Right to Know post, one commenter referred to COVID-19 as the “China virus” and President Biden as “China Joe.”
Peter Hotez, a vaccine scientist and misinformation expert with Baylor College of Medicine points out that the uproar over gain-of-function research plays right into the conservative narrative about greedy pharma companies and power-hungry scientists. Hotez notes that the right-leaning anti-vaccine groups that he tracks have begun to embrace anti-GMO rhetoric, insisting that mRNA vaccines genetically modify humans. (They don’t.) “In the past we said, ‘this is far left and far right,’ but I am seeing more far-right dominance. It’s becoming much more of a mainstream GOP dynamic.”
Kimbrell doesn’t see it this way. His group has always attracted a small contingent of libertarians, he said, accounting for perhaps 5 or 10 percent of the supporters. He noted that he has encouraged his staff to get vaccinated against COVID-19; he opted for the Johnson & Johnson shot because he was skeptical of the mRNA technique the Moderna and Pfizer used to develop their shots. “We’re bipartisan, we’re trying to have humans, as a species, live in a mutually enhancing world with the rest of nature, and that’s generally viewed as progressive,” he said. “I’m not quite sure why.”
Progressives have a long history of advocating for diplomacy and cooperation over threats and hostile overtures. But these are strange times, with the far left and the far right bonding over vaccines, and conspiracy theories, and now, pandemic virology research. This dynamic can be dangerous not only to science, but also to the researchers who conduct this work.
In recent months, the paranoia about EcoHealth has spilled over into Daszak’s personal life. He and his staff have received dozens of death threats. After someone sent an envelope of white powder to his home, he decided to hire security personnel to protect his family.
Baylor’s Hotez noted that threats to scientists have increased dramatically over the past year. He says that when prominent activists cast scientists as evil power brokers, it fosters an atmosphere of animosity toward researchers. “Anti-science groups are trying to paint a picture of scientists as evildoers rather than the humanitarians that most of us are,” he said. “Most of us became scientists to help, to do something for humanity.” Hotez himself has received many recent threats related to his vaccine advocacy, some of them anti-Semitic in nature.
Beyond his own personal safety, Daszak worries about the implications for infectious disease research: If the United States stops virology work in China it’s likely scientists’ access “to a place where these viruses come from” will be blocked. The tensions over the lab-leak theory may escalate to the point where scientific cooperation breaks down. And we’ll certainly never get to conduct a thorough investigation into the origins of the pandemic, Boston University’s Keusch said, noting, “The best hope is that somehow in the back channels, we will figure out how to lower the heat, increase the light, convince the Chinese it’s in their interest to be transparent.”
Will the diplomatic back channels prevail in time to prevent the next pandemic? That’s anybody’s guess, because pathogens emerge, change, and spread all around us, all the time. Just last week, Chinese authorities reported the first human case of a rare bird flu. The idea that the United States wouldn’t be able to monitor and study this pathogen alarms Daszak. “If we don’t do that work, it’s really damaging to future public health risk,” he said. “We’ll never know what’s coming next.”